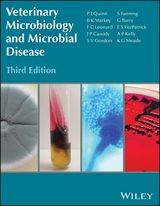
Veterinary Microbiology and Microbial Disease - Quinn, P J

Veterinary Microbiology and Microbial Disease
Wiley-Blackwell (Verlag)
978-1-4051-5823-7 (ISBN)
Key features of this edition:
Twelve new chapters included
Numerous new illustrations
Each chapter has been updated
Completely re-designed in full colour
Fulfils the needs of veterinary students and academics in veterinary microbiology
Companion website with figures from the book as Powerpoints for viewing or downloading by chapter: www.wiley.com/go/quinn/veterinarymicrobiology
Veterinary Microbiology and Microbial Disease remains indispensable for all those studying and teaching this essential component of the veterinary curriculum.
P.J. Quinn, B.K. Markey, W.J. Donnelly, F.C. Leonard, S. Fanning and D. Maguire
Preface ix Acknowledgements x
Author biographies xi
Section I Introduction to Microbiology,
Infection, Immunity and Molecular
Diagnostic Methods
1 Microbiology, microbial pathogens
and infectious disease 3
2 Subdivisions, classifi cation and morphological characterization of infectious agents 7
3 Infection and immunity 14
4 Immunodefi ciency diseases 67
5 Vaccines and vaccination 80
6 Molecular diagnostic methods 95
Section II Introductory Bacteriology
7 The structure of bacterial cells 115
8 Cultivation, preservation and inactivation of bacteria 123
9 Bacterial genetics, mechanisms of genetic variation and gene databases 129
10 Laboratory diagnosis of bacterial disease 143
11 Antibacterial agents 149
12 Antibacterial resistance 157
13 Bacterial colonization, tissue invasion and clinical disease 165
Section III Pathogenic Bacteria
14 Staphylococcus species 179
15 Streptococci 188
16 Actinobacteria 196
17 Corynebacterium species 207
18 Rhodococcus equi 213
19 Listeria species 217
20 Erysipelothrix rhusiopathiae 222
21 Bacillus species 227
22 Clostridium species 233
23 Mycobacterium species 250
24 Enterobacteriaceae 263
25 Pseudomonas aeruginosa and Burkholderia species 287
26 Actinobacillus species 293
27 Pasteurella species, Mannheimia haemolytica and Bibersteinia trehalosi 300
28 Francisella tularensis 309
29 Histophilus somni, Haemophilus parasuis and Avibacterium paragallinarum 314
30 Taylorella species 321
31 Bordetella species 325
32 Moraxella species 330
33 Brucella species 334
34 Campylobacter and Helicobacter species 342
35 Lawsonia intracellularis 351
36 Spirochaetes 354
37 Pathogenic anaerobic non-spore-forming Gram-negative bacteria 367
38 Mycoplasmas 373
39 Chlamydia and Chlamydophila species 384
40 Rickettsiales and Coxiella burnetii 394
41 Bacterial species of limited pathogenic signifi cance 405
Section IV Mycology
42 General features of fungi associated with disease in animals 413
43 Dermatophytes 419
44 Aspergillus species 425
45 Yeasts and disease production 430
46 Dimorphic fungi 439
47 Zygomycetes of veterinary importance 446
48 Fungus-like organisms of veterinary importance 452
49 Pneumocystis carinii 457
50 Opportunistic infections caused predominantly by phaeoid fungi 459
51 Mycotoxins and mycotoxicoses 463
52 Pathogenic algae and cyanobacteria 478
53 Antifungal chemotherapy 483
Section V Introductory Virology
54 Nature, structure and taxonomy of viruses 505
55 Replication of viruses 514
56 Genetics and evolution of viruses 522
57 Propagation of viruses and virus–cell interactions 527
58 Pathogenesis of viral diseases 534
59 Laboratory diagnosis of viral infections 541
60 Antiviral chemotherapy 548
Section VI Viruses and Prions
61 Herpesviridae 567
62 Papillomaviridae 583
63 Adenoviridae 588
64 Poxviridae 593
65 Asfarviridae 603
66 Parvoviridae 607
67 Circoviridae 615
68 Retroviridae 618
69 Reoviridae 635
70 Birnaviridae 644
71 Orthomyxoviridae 647
72 Paramyxoviridae 656
73 Rhabdoviridae 668
74 Bornaviridae 676
75 Bunyaviridae 679
76 Picornaviridae 684
77 Caliciviridae 692
78 Astroviridae 698
79 Coronaviridae 700
80 Arteriviridae 713
81 Flaviviridae 718
82 Togaviridae 729
83 Prions: unconventional infectious agents 734
Section VII Microbial Agents and Disease Production
84 Tissue and system preferences of bacterial, fungal and viral pathogens and the nature of the diseases caused by these infectious agents 745
85 Interactions of microbial pathogens with the nervous system 759
86 Interactions of microbial pathogens with the male and female reproductive systems 765
87 The role of microbial pathogens in intestinal disease 773
88 The role of microbial pathogens in respiratory disease 778
89 Interactions of microbial pathogens with the renal system 787
90 Microbial diseases of the cardiovascular system 797
91 Interactions of microbial pathogens with the musculoskeletal system 806
92 The role of microbial pathogens in diseases of the integumentary system 826
93 Bacterial causes of bovine mastitis 837
94 Disinfection, biosecurity and other aspects of disease control 851
Appendix: Relevant websites 890
Index 893
| Erscheint lt. Verlag | 14.10.2011 |
|---|---|
| Verlagsort | Hoboken |
| Sprache | englisch |
| Maße | 218 x 277 mm |
| Gewicht | 2540 g |
| Themenwelt | Veterinärmedizin ► Klinische Fächer ► Mikrobiologie / Immunologie |
| Veterinärmedizin ► Klinische Fächer ► Parasitologie | |
| ISBN-10 | 1-4051-5823-9 / 1405158239 |
| ISBN-13 | 978-1-4051-5823-7 / 9781405158237 |
| Zustand | Neuware |
| Informationen gemäß Produktsicherheitsverordnung (GPSR) | |
| Haben Sie eine Frage zum Produkt? |
aus dem Bereich